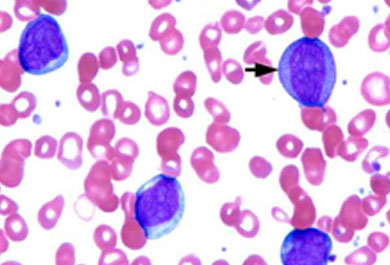

DISEASES
Yoga Vana Hills is affirmative that it could cure more than 4500+ diseases with the use of herbal and natural treatments. For all those conditions that have been referred to as incurable, Yoga Vana Hills provides you the solution.
Chitradurga
Seebara, Behind Indian Oil Petrol Bunk, Basavakumara Swamy Mutt, Chitradurga - 577504
Kunigal
K Huraliborsandra, Gowdgere Post, Dhomratti Temple Road, Kunigal, Tumakuru District. - 572130
Bengaluru
36, KG Gollarapalya, Bolare (P), Kanakapura Road, Bengaluru - 560082